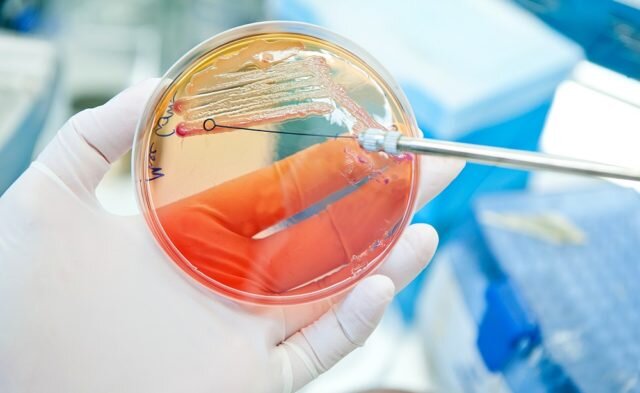
آزمایش کشت ادرار چگونه انجام می شود؟ - سلامت نیوز

دریافت فایل مقاله پژوهشی تاثیر ژل پلاکتی در درمان زخم پای دیابتی
عنوان فایل: مقاله پژوهشی تاثیر ژل پلاکتی در درمان زخم پای دیابتی تعداد صفحات: 9 صفحه مقاله تایپ شده فرمت: pdf ارائه شده: سایت یوفایل

لطفا برای مطالعه متن کامل مقاله به سایت مربوطه در قسمت دریافت فایل و دانلود در همین صفحه مراجعه فرمایید.